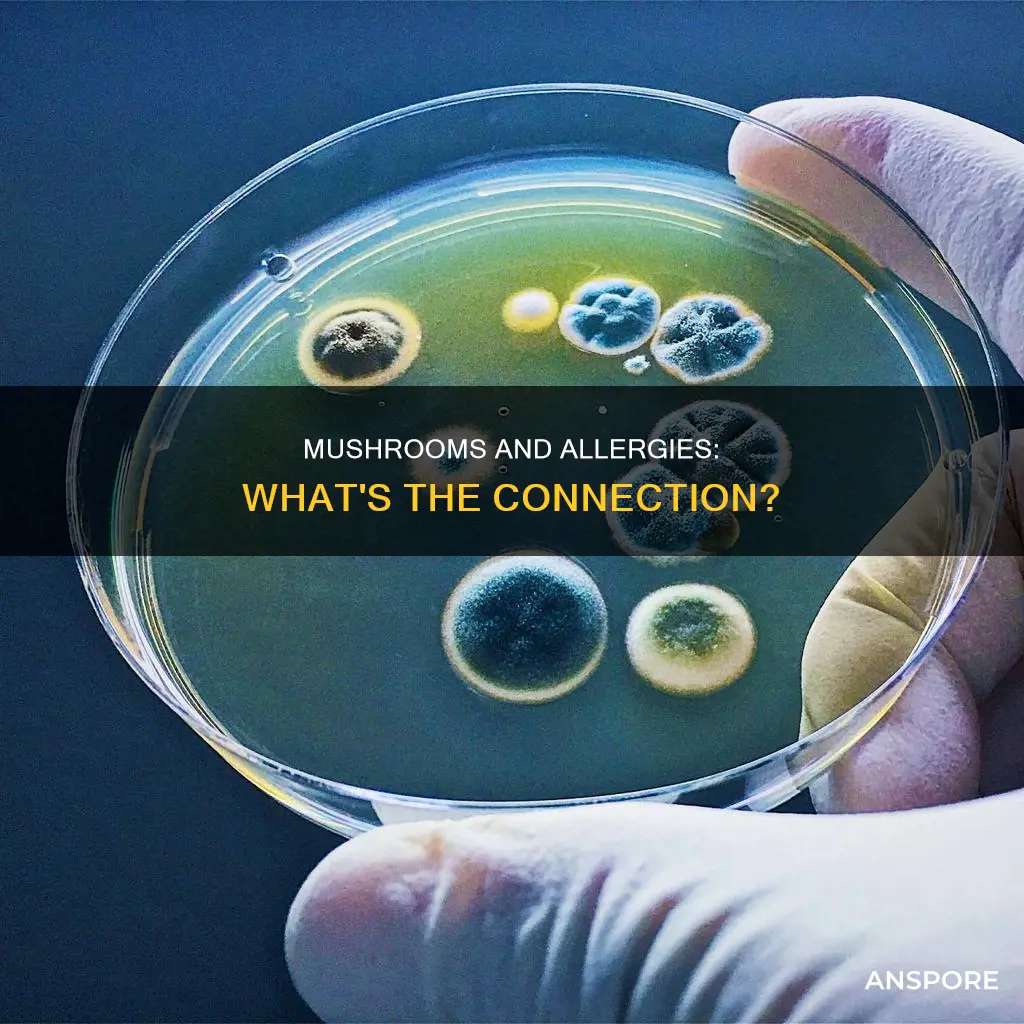
will mushrooms irritate allergies

Mushrooms are often considered a delicacy and are sought after for their flavour and nutritional value. However, they can also be a source of allergies for some people. Mushroom allergies are triggered by an immune system response to the proteins in mushrooms, and the symptoms can range from mild to severe and even life-threatening in some cases. The primary cause of mushroom allergies is exposure to mushroom spores, which can occur through consumption, inhalation, or skin contact. While the overall extent of mushroom allergies is not known, it is estimated that it could be as prevalent as pollen and mould allergies, affecting 10-30% of the allergic population.
| Characteristics | Values |
|---|---|
| Allergy type | Food allergy, airborne allergy |
| Allergy symptoms | Oral allergy syndrome, anaphylaxis, hives, itching, swelling of the throat, tongue, mouth, or lips, breathing difficulties, sneezing, runny nose, itchy eyes, asthma attacks, skin rash, stomach pain, wheezing, dizziness, rapid heartbeat, severe abdominal pain, sudden drop in blood pressure, nasal congestion, minor digestive issues, diarrhea |
| Allergy diagnosis | Skin tests, blood tests, skin prick test |
| Allergy treatment | Avoidance of mushrooms, antihistamines, epinephrine, steroids, immunotherapy |
| Allergy prevalence | Unknown, possibly very slight (1%) or as prevalent as pollen and mould allergies (10-30%) |
| Allergen sources | All species studied so far have yielded positive results. Allergen contamination by other sources is frequent. |
| Related allergies | Mould allergy, pollen allergy, yeast, aged cheese, mildew |
Explore related products
What You'll Learn

Mushroom allergy symptoms
More severe symptoms can indicate an anaphylactic reaction, which requires immediate medical attention. These symptoms include difficulty breathing, wheezing, dizziness, rapid heartbeat, severe abdominal pain, and a sudden drop in blood pressure. Inhalation of airborne mushroom spores can also lead to respiratory allergies, causing symptoms such as sneezing, coughing, wheezing, and shortness of breath. These symptoms can be particularly problematic for individuals with pre-existing respiratory conditions like asthma.
The most common allergenic proteins found in mushrooms are usually associated with the fungi's reproductive spores, which can become airborne and cause respiratory issues in sensitive individuals. The cultivated mushroom, for example, has been linked to anaphylaxis due to the presence of mannitol and IgE-mediated allergies. Oral allergy syndrome (OAS) can also occur in individuals who are sensitive to both raw mushrooms and certain environmental allergens, leading to specific IgE responses. Common symptoms include itching, hives, swelling of the lips, face, or throat, and gastrointestinal distress such as nausea, vomiting, or diarrhea.
If you suspect that you have a mushroom allergy, it is important to seek a professional diagnosis and consult with an allergist. Skin tests and blood tests can be performed to identify the specific allergen causing the allergy. The most effective treatment for mushroom allergies is to avoid mushrooms altogether. Antihistamines can be used to treat mild allergy symptoms, but they are not effective in the case of anaphylaxis.
Mushrooms' Temperature Tolerance: Thriving and Dying Conditions
You may want to see also

Mushroom allergy diagnosis
During a skin test, a small amount of the suspected allergen, in this case, mushroom extract, is pricked or scratched into the skin. If the skin develops a raised, red, itchy bump, it indicates that the person is allergic to mushrooms. Skin tests provide immediate results, but they may not always be conclusive as there are difficulties in mushroom allergen research due to the risk of allergenic contamination by other sources.
Blood tests measure the amount of Immunoglobulin E (IgE) antibodies in the blood. High levels of IgE antibodies suggest an allergic reaction to mushrooms. However, blood test results are typically available only after a few days.
The most effective treatment for a mushroom allergy is to avoid mushrooms altogether. Individuals with this allergy should be careful to avoid all types of mushrooms and read food labels carefully to ensure that they are not consuming any hidden ingredients that may trigger an allergic reaction.
It is important to note that the overall extent of mushroom allergies is not precisely known. However, allergic reactions to mushrooms can range from mild to severe and can even be life-threatening in some cases. If an individual experiences symptoms of an allergic reaction after consuming or coming into contact with mushrooms, they should consult a healthcare professional for diagnosis and treatment.
Microdosing Mushrooms: Legal or Not?
You may want to see also

Mushroom allergy treatment
Mushroom allergy symptoms can range from mild to severe and can be life-threatening in some cases. The most effective treatment for a mushroom allergy is to avoid mushrooms altogether. This includes not only avoiding eating mushrooms but also avoiding areas where mushrooms are grown or processed. It is important to read food labels carefully and ask about ingredients in restaurants, as mushroom is a common ingredient in many dishes.
If an individual experiences symptoms of a mushroom allergy, they should consult an allergist for diagnosis and treatment. The allergist will perform a physical examination and review the patient's medical history. Skin tests and blood tests can then be used to identify the specific allergen causing the allergy. A skin test involves exposing the skin to a small amount of mushroom allergen to see if a reaction occurs. A blood test measures the amount of immunoglobulin E (IgE) antibodies in the blood, with high levels indicating an allergy.
Medications are often the first line of treatment for mushroom allergies. Over-the-counter (OTC) antihistamines can help alleviate mild symptoms such as hives, itching, runny nose, sneezing, and digestive issues. For more severe symptoms, doctors may prescribe corticosteroids to reduce inflammation. In the case of anaphylaxis, a life-threatening allergic reaction, epinephrine (adrenaline) should be administered immediately.
Allergy shots, also known as allergen immunotherapy, involve injecting small doses of the allergen into the body to build up immunity over time. This treatment is typically recommended for patients with severe allergies or those who don't respond well to medications. Another treatment option is sublingual immunotherapy, which involves placing a tablet containing the allergen under the tongue. While there is currently no cure for mushroom allergies, immunotherapy treatments aim to gradually expose the immune system to small amounts of the allergen to build tolerance over time.
Wine and Mushroom Risotto: A Perfect Pairing Guide
You may want to see also
Explore related products

Mushroom allergy prevalence
The overall extent of mushroom allergy is unknown. It may be very slight (1%) from consuming mushrooms, but it could be as prevalent as pollen and mould allergies (10-30% of an allergic population) when inhaled. Mushroom allergy is an immune system response to the proteins in mushrooms. The primary cause of mushroom allergy is that the body interprets the mushroom proteins as foreign. The immune system releases IgE antibodies to combat these foreign proteins, causing the release of histamine, which can lead to a variety of allergy symptoms.
The allergic reaction is caused either by eating mushrooms or inhaling their spores. Different species of mushrooms, from Shiitake to Button mushrooms, can cause various symptoms. Consuming mushrooms can trigger skin irritation, hives, and rashes. Some people have also reported swelling of the lips, mouth, and throat due to mushrooms. Swelling of the throat can cause breathing difficulties. A severe allergic reaction or anaphylaxis can occur, requiring immediate clinical assistance. Inhalation of mushroom spores can cause upper respiratory tract inflammation, leading to a runny nose, watery eyes, and wheezing.
Skin tests and blood tests can be performed to identify mushroom allergies. Skin tests involve exposing the skin to small amounts of mushroom allergens. If the skin develops a raised, red, itchy bump, it indicates a mushroom allergy. Blood tests measure the amount of IgE antibodies in the blood, with high levels suggesting an allergy.
The most effective treatment for mushroom allergies is avoidance. Individuals with mushroom allergies should avoid all mushroom types, including Shiitake, Portobello, White Button, and Oyster mushrooms. Mushroom is a common ingredient in many dishes, so it is important to read food labels carefully and ask about ingredients in restaurants. Antihistamines can help relieve mild allergy symptoms such as hives and itching, but they do not treat anaphylaxis. Anaphylaxis is a life-threatening allergic reaction requiring immediate treatment with epinephrine.
Mushroom Magic: Are Mushrooms Keto-Friendly?
You may want to see also

Mushroom allergy and airborne allergens
Mushroom allergy symptoms can range from mild irritation to severe respiratory distress. They can include sneezing, skin rashes, and even life-threatening reactions. The symptoms may begin subtly and can be mistaken for seasonal allergies or mild food intolerances. For instance, mild allergy symptoms include hives and itching, which can be treated with antihistamines. On the other hand, severe allergic reactions, such as anaphylaxis, require immediate treatment with epinephrine.
A mushroom allergy is an immune system response to the proteins or molds in mushrooms. It is important to distinguish between a mushroom allergy and a mold allergy. While both involve fungi, they are not always linked. A person allergic to mold may not necessarily react to mushrooms, and vice versa.
Fungus-related foods, such as edible mushrooms, mycoprotein, and fungi-fermented foods, can cause fungus food allergy syndrome (FFAS) by allergic cross-reactivity with airborne fungi. FFAS may involve one or more target organs, with various allergy symptoms ranging from oral allergy syndrome to severe anaphylaxis.
Airborne spores from dried or uncooked mushrooms can also trigger symptoms, especially in more severe cases. Mushroom aerosporas and other woodland fungi, mostly basidiospores, occur in temperature zones in June to November, reaching maximums in August and September in quantities comparable to pollen and mould spores.
If an individual suspects a mushroom allergy, they should consult an allergist for diagnosis and treatment. Diagnosis typically involves skin prick tests, blood tests, and elimination diets.
Kosher Mushrooms for Passover: What You Need to Know
You may want to see also
Frequently asked questions
Yes, mushrooms are allergens for some people. They are fungus-related foods that can cause fungus food allergy syndrome (FFAS) by allergic cross-reactivity with airborne fungi.
Symptoms of a mushroom allergy can range from mild to severe, depending on an individual's sensitivity. Mild symptoms may include a skin rash, itching, hives, sneezing, nasal congestion, and minor digestive issues such as stomach discomfort. More severe symptoms may include anaphylaxis, which is life-threatening and requires immediate medical attention.
The overall extent of mushroom allergy is not known. It may be very slight (1%) from eating, but could be as prevalent as pollen and mould allergies (10-30% of an allergic population) when inhaled.
If you experience any symptoms of a mushroom allergy, you should consult with an allergist for diagnosis and treatment. Skin tests and blood tests can be conducted to identify the specific allergen causing the allergy.

























